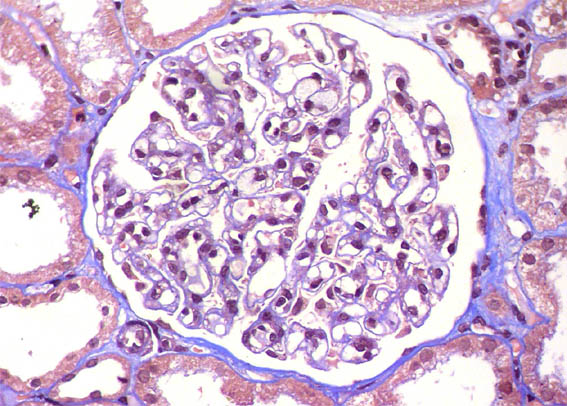

|
|
CASE
145 (March 2018)
Clinical information
A 24-year-old woman in her first pregnancy develops arterial hypertension and proteinuria during the 26th week of gestation. Hypertension becomes difficult to control, with fetal distress, so cesarean is done at week 33 of gestation. The proteinuria reached 2.9 g/24h. After the cesarean, serum creatinine rises from 1.0 mg/dL to 1.7 mg/dL.
Two weeks after finishing the pregnancy, high pressure was 140/90 and proteinuria persisted: 2.7 g/24h, with serum cretinine: 1.4 mg/dL, for which a renal biopsy was performed.
There is no pathological personal history. Negative autoimmunity studies. There were no alterations in liver tests or in coagulation tests, platelets always in normal values.
See the images.

Figure 1. H&E , X200.

Figure 2. PAS, X100.

Figure 3. PAS, X400.

Figure 4. PAS, X400.

Figure 5. PAS, X400.

Figure 6. Masson's trichrome, X400.
Figure 7. Masson's trichrome, X400.

Figure 8. Methenamine-silver, X400.

Figure 9. Methenamine-silver, X400.

Figure 10. Methenamine-silver, X400.

Figure 11. H&E, X400.
Immunofluorescence for IgA, IgG, IgM, C3, C1q, kappa, and lambda: Negative.
What is your diagnosis?
See
diagnosis and discussion
[Top]
|
|